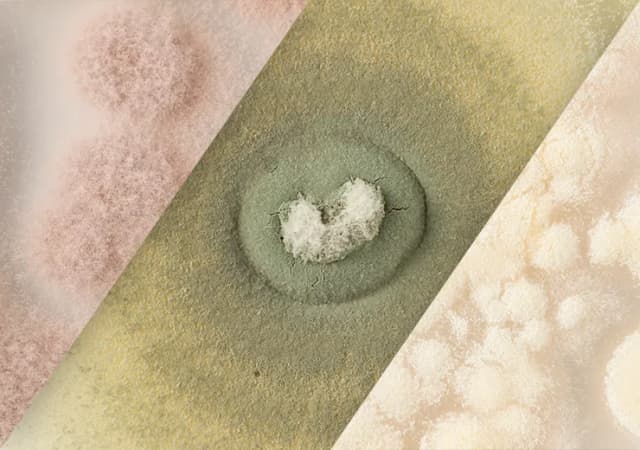
Insumos Biológicos Insumos Biológicos

Com apoio da Finep, empresa desenvolve aplicativo para reconhecimento de pragas
Texto de autoria do jornal Sucesso no Campo, leia na íntegra: https://sucessonocampo.com.br/com-apoio-da-finep-empresa-desenvolve-aplicativo-para-reconhecimento-de-pragas/. A inteligência artificial está cada vez mais presente em nosso dia a dia. E, com o intuito de auxiliar o produtor na identificação e no controle de pragas, a Pragas.com – provedora de soluções para controle biológico – desenvolveu um aplicativo de reconhecimento […]